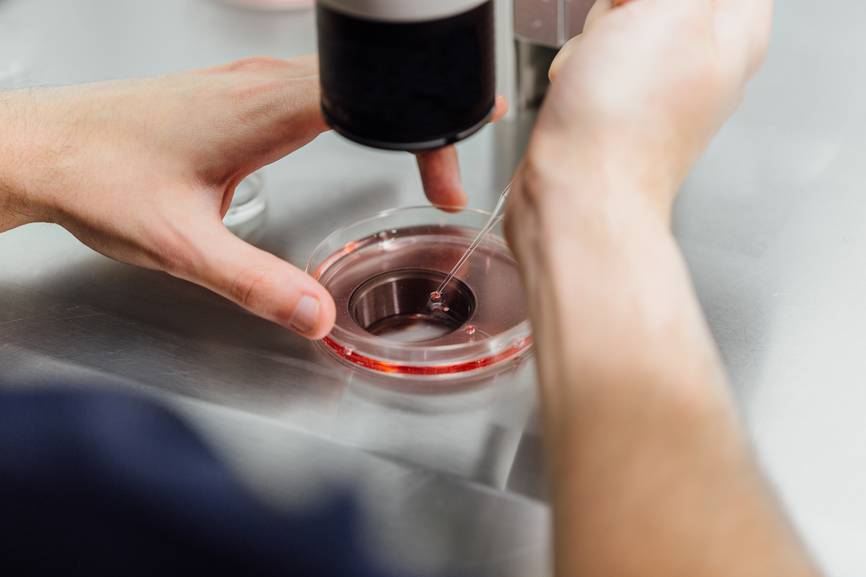

АФС и его влияние на беременность
В случае беременности патология может спровоцировать гибель эмбриона, выкидыш, отслойку плаценты, гипоксию плода и патологии внутриутробной локации. Многочисленные исследования доказали, что одной их главных причин прерывания беременности считается плацентарная недостаточность. И если она проявилась клинически, любое лечение будет бесполезным.

Лечить данный недуг надо уже на протяжении первых месяцев беременности. Такая срочность объясняется тем, что неправильная свертываемость крови провоцирует накопление фибрина в сосудах плаценты. Терапевтические методы заблокируют образования фибрина, но не смогут удалить из сосудов уже накопившийся «мусор» и не приведут их в норму.
Диагностика АФС
Критерии антифосфолипидного синдрома
антифосфолипидного синдромадиагностикелабораторные
| Клинические критерии АФС | Лабораторные критерии АФС |
| Сосудистый тромбоз – один или более эпизод тромбоза мелких сосудов любого органа или ткани. При этом наличие тромбов должно быть подтверждено допплерометрией, методами визуализации или гистологическим исследованием биопсии пораженного участка органа/ткани. | Антитела к кардиолипину (АКА, аКЛ) типов IgM и IgG, которые были выявлены в повышенных титрах минимум дважды в течение 12 недель. Повторные исследования уровня антител проводятся с интервалом минимум в 6 недель. То есть для правильной диагностики АФС между двумя последовательными анализами на антитела к кардиолипину должно пройти не менее 6 недель, но и не более 12 недель. |
Патология беременности (нижеприведенные пункты нужно читать через союз «или»):
|
Волчаночный антикоагулянт (ВА), который был выявлен в повышенных титрах минимум дважды в течение 12 недель. Повторные исследования уровня волчаночного антикоагулянта проводятся с интервалом минимум в 6 недель. То есть для правильной диагностики АФС между двумя последовательными анализами на волчаночный антикоагулянт должно пройти не менее 6 недель, но и не более 12 недель. Определение концентрации волчаночного антикоагулянта должно проводиться по тесту Рассела с ядом гадюки (dRVVT), поскольку именно этот метод является международно стандартизированным. |
| Антитела к бета-2-гликопротеину-1 типов IgM и IgG, которые были выявлены в повышенных титрах минимум дважды в течение 12 недель. Повторные исследования уровня антител проводятся с интервалом минимум в 6 недель. То есть для правильной диагностики АФС между двумя последовательными анализами на антитела к бета-2-гликопротеину-1 должно пройти не менее 6 недель, но и не более 12 недель. |
антителасимптомы
ОРВИстрессАнтифосфолипидный синдром следует различать со следующими заболеваниями, имеющими сходные клинические симптомы:
- приобретенные и генетические тромбофилии;
- дефекты фибринолиза;
- злокачественные опухоли любой локализации, в том числе крови;
- атеросклероз;
- эмболии;
- инфаркт миокарда с тромбозом желудочков сердца;
- кессонная болезнь;
- тромботическая тромбоцитопеническая пурпура (ТТП) / гемолитико-уремический синдром (ГУС).
Какие анализы и как сдавать (маркеры антифосфолипидного синдрома)
здоровьяпростылдиетыкурениеменструального циклаДля диагностики антифосфолипидного синдрома необходимо сдать следующие анализы:
- антитела к фосфолипидам типов IgG, IgM;
- антитела к кардиолипину типов IgG, IgM;
- антитела бета-2-гликопротеину 1 типов IgG, IgM;
- волчаночный антикоагулянт (оптимально, чтобы данный параметр в лаборатории определялся по тесту Рассела с ядом гадюки);
- антитромбин III;
- общий анализ крови с количеством тромбоцитов;
- коагулограмма (АЧТВ, микст-АЧТВ, ТВ, МНО, каолиновое время, фибриноген);
- реакция Вассермана (результат будет положительным при АФС).
тромбозов
Отклонение результатов от нормы
Низкое или умеренное содержание антител в сыворотке крови, чаще всего, указывает на прием медикаментозных препаратов. Патологией считается, если концентрация антифосфолипидных антител удерживается на высоком уровне в течение длительного времени, что подтверждается повторным анализом. Диагноз АФС ставится на фоне специфических клинических проявлений, если подтверждается наличие антител в сыворотке крови. Это очень опасное заболевание, которое до настоящего времени окончательно не изучено.

При беременности — болезнь предупреждает о высоких рисках развития осложнений во время вынашивания ребенка. Опасным последствием антифосфолипидного синдрома является тромбоз сосудов плаценты.
На фоне этого возникают различные гинекологические патологии. Особенно опасным является такой диагноз, поставленный в период вынашивания ребенка. Он указывает на то, что у женщины может возникнуть самопроизвольный выкидыш в любой момент, но, чаще всего, потеря плода происходит во II и III триместрах.
Женщинам, которым поставлен диагноз АФС, грозит бесплодие, а если даже удастся забеременеть, то велик риск внутриутробной гибели плода или преждевременных родов. Клиническим проявлением повышения антител являются постоянные спонтанные выкидыши.
Клиническая картина
При АФС клинические проявления могут быть разными, и общая картина зависит от следующих факторов:
- Размеров поврежденных сосудов.
- Скорости закупорки сосудов.
- Функционального назначения сосудов.
- Местонахождения сосудов.
На кожных поверхностях при АФС могут наблюдаться такие изменения:
- Сосудистая сетка на кистях и ступнях.
- Сыпь в виде точек.
- Наличие подкожных гематом.
- Длительно незаживающие язвенные поражения кожных поверхностей.
- Подкожные узелки.
Повышение антител всегда предупреждает о возможном развитии тромбозов. При этом повреждения могут затрагивать любые сосуды, но наиболее распространенным является венозный тромбоз. Тромбы, чаще всего, локализуются в глубоких венах нижних конечностей, но иногда такие патологии затрагивают печеночные, портальные или поверхностные вены.

На фоне повреждений сосудов легких, часто развивается легочная гипертензия. Тромбоз главной вены надпочечников с дальнейшим возникновением геморрагий и инфаркта способствует возникновению надпочечниковой недостаточности.
Возникающие при АФЛ тромбы в артериях наиболее опасны для сосудов головного мозга. Это приводит, чаще всего, к возникновению инсульта. Причем такая опасная патологии очень часто поражает людей в молодом возрасте, без каких-либо предрасполагающих факторов.
Прогноз при АФС неоднозначен. Успех лечения зависит от многих факторов
Прежде всего, важно своевременно сдать крови на исследование с целью определения уровня антител. Только на базе результатов исследования крови и клинических проявлений может быть назначено правильное лечение врачом-ревматологом
Но при этом следует учитывать, что обязательно нужна будет консультация многих специалистов, в связи с тем, что эта болезнь затрагивает многие органы.
Опасность АФС для человеческого здоровья
Для людей с завышенной нормой антител характерно поражение сосудистой системы таких органов:
- Сердце.
- Головной мозг.
- Почки.
- Надпочечники.
Возможность развития венозных тромбозов и инфаркта миокарда возрастает на 34 процента. У многих пациентов нарушается мозговое кровообращение, из-за которого может развиваться инсульт, неврологические патологии и поражения эпителия.
В мире около 17 процентов населения имеют превышение нормы антител к фосфолипидам. Если данное отклонение фиксируется у беременных, то при отсутствии правильного лечения у 86 процентов из них будет выкидыш или замирание развития эмбриона. В нашей стране у будущих мам, имеющих антитела к кардиолипинам, прерывание беременности происходит в 33 процентах случаев.
Советуем прочитать:
Делитесь опытомПланирование беременности: анализ и обследования, зачатие, бесплодие, невынашивание Например, антитела к бетта-чего-то там и прочее. Понимаете, антитела к фосфолипидам Беременность при АФС. Может кто-нибудь поделиться своим опытом беременности с АФС ?
Антифосфолипидный синдромАнтифосфолипидный синдром. Медицинские вопросы. Планирование беременности. Диагноз: » Антифосфолипидный синдром «. При антифосфолипидном синдроме ( АФС ) у женщин с привычным невынашиванием беременности, внутриутробной гибелью плода или…
опять АФС (((Фосфолипиды — общее название перечисленных вами анализов. Однократное повышение фосфолипидов — не повод ставить себе диагноз афс Вопросики про антиХГ и АФС ? И надо бы мне сдать анализы на антитела к хорионическому гонадотропину человека (анти-ХГ, IgM и…
Девочки, подскажите, показывает ли аналиНужно отдельно сдавать антитела к фосфолипидам. «Когда ставят диагноз АФС ? Условия постановки диагноза АФС : — наличие как минимум одного клинического (симптомы) и одного лабораторного признака ( анализы ); — антифосфолипидные тесты должны быть позитивными…
Завтра иду на скрининг+ анализы. Вопросики про антиХГ и АФС?Вопросики про антиХГ и АФС ?. Анализы, исследования, тесты, УЗИ. Беременность и роды. Зажмите, пожалуйста кулачки ваши волшебные! И надо бы мне сдать анализы на антитела к хорионическому гонадотропину человека (анти-ХГ, IgM и IgG) и антитела к фосфолипидам …
АФС или ?Врачи в Москве поставили АФС (резкоположительные результаты на фосфолипиды ), волчаночный тест отрицательный, выше нормы в 2 раза антитела к ХГЧ. НЕобходимо сдать анализы на антитела к папиломевирусу и на антигены к папиломевирусу с цифрами.
Антифосфолипидный синдром кто знает??HLA типирование, кариотип, + диагностика антифосфолипидного синдрома +волчаночный антикоагулянт. врач делал очень Антифосфолипидный синдром есть у кого?. Медицинские проблемы. Планирование беременности. Я так поняла, у вас только цифры в анализах выше.
Вопрос Марии ММ антитела к фосфолипидамПодскажите, пожалуйста, готовясь к беременности, я сдала анализ на антитела к фосфолипидам и в результате узнала надо простоповрить, афс могут быть положительными во время вирусной инфекцции… если так и будут все время высокоими, эито надо будет миеть…
АФССовременная концепция диагностики афс предусматривает не менее двух анализов с интервалом не менее двух месяцев + как АФС — состояние, когда антитела к фосфолипидам начинают вырабатываться бесконтрольно и убивают хорошие клетки (аутоагрессия).
Антифосфолипидный синдром: рекомендации и лечение
Основная цель при лечении АФС – это профилактика тромбоэмболических осложнений и рецидивов тромбозов. Заниматься лечением АФС должен ревматолог и гематолог.
Пациентам с антифосфолипидным синдромом рекомендовано избегать травм, отказаться от занятий опасными и травматичными видами спорта, избегать длительных авиаперелетов, оказаться от курения и злоупотребления спиртными напитками.
Женщинам с антифосфолипдным синдромом следует отказаться от приема оральных контрацептивов.
Лечение и профилактика АФС непрямыми (варфарин) и прямыми (гепарин) антикоагулянтами, а также антиагрегантами (аспирин) проводится под лабораторным контролем показателей гемостаза.
По показаниям может проводиться плазмаферез, переливание препаратов свежезамороженных препаратов плазмы, назначение глюкокортикоидов, иммуноглобулинов.
Прогноз при антифосфолипидном синдроме
При своевременном начале лечения и грамотной профилактике рецидивов тромбозов, прогноз благоприятный.
Неблагоприятный прогноз чаще всего отмечается у пациентов с АФС на фоне СКВ, тромбоцитопений, стойких артериальных гипертензий, а также у лиц, у которых быстро нарастают титры антител к кардиолипину.
Что это за анализ
Самостоятельно понять, что в человеческом организме происходит выработка антител к фосфолипидам, невозможно. Недомогание и проблемы со здоровьем, как правило, объясняются вирусной инфекцией или дисфункцией определенных органов и систем. В связи с этим для определения количества антител обязательно нужно сделать анализ крови в специализированной лаборатории.

На основании анализа крови на антитела к фосфолипидам (класс IgG и IgM) специалисты получают важный показатель, который позволяет своевременно диагностировать тяжелое аутоиммунное нарушение. Благодаря этому, можно своевременно назначить правильное лечение и исключить тяжелые осложнения.
В процессе исследования плазмы крови доктор определяет наличие антител к следующим видам фосфолипидов:
- Отрицательно заряженным — фосфатидилсерину, кардиолипину.
- Положительно заряженным — фосфатидилинозитолу и фосфатидиловой кислоте.
- Нейтральным — фосфатидилхолину.
Суть анализа
Анализ на антифосфолипидные антитела требуется для выявления специфического белка, который организм образует против себя самого в результате аутоиммунных реакций. В свою очередь фосфолипиды являются неотъемлемой составной частью клеток организма. Эти элементы входят непосредственно в клеточный состав мембран и тромбоцитов. Они, по сути, являются молекулами жира, который играет ключевую роль в кровяном свертывании, правда, механизм их воздействия остается до настоящего времени невыясненным. Антифосфолипиды повышают риски нарушения кровяного свертывания и формирования тромбов в венах и артериях, что может приводить к инсультам и инфарктам.
Наличие антифосфолипидных антител тоже связано с возникновением тромбоцитопении (сниженного содержания в крови тромбоцитов), с рисками повторных выкидышей (в особенности в последней трети беременности), а также с токсикозами на последней стадии беременности и с преждевременными родами.
Присутствие данных антител служит частью симптоматического комплекса, который называют антифосфолипидным синдромом или болезнью Стовина. Также в него включаются тромбозы наряду с акушерскими патологиями (выкидышами, привычным невынашиванием беременности) и тромбоцитопенией. Данный синдром может быть напрямую связан с прочими аутоиммунными заболеваниями, особенно с системной волчанкой или развивается без сопутствующих заболеваний (тогда говорят о первичном антифосфолипидном синдроме).
Правда, антитела часто появляются в человеческом организме и при таком аутоиммунном расстройстве, как красная волчанка, кроме этого, их могут наблюдать и при наличии у человека ВИЧ-инфекции, некоторых форм рака, употреблении определенных лекарственных препаратов, к примеру, фенотиазинов и новокаинамида. В связи со всем этим определение антикардиолипиновых антител выступает дополнительным анализом и само по себе их наличие не считается диагностическим прямым критерием антифосфолипидного синдрома. Стоит отметить, что анализы, ровно, как и диагностика этого синдрома в целом должна быть комплексной, включающей в себя сразу несколько определенных клинических показателей.
Диагностика антифосфолипидного синдрома: зачем нужны два теста с таким большим перерывом?
Кратковременный равномерный подъем содержания всех эмбриотропных антител наблюдается при острых инфекционно-воспалительных заболеваниях (бактериальных или вирусных). По мере затухания болезни (через 1-3 нед.) показатели содержания антител обычно возвращаются к норме. Такие кратковременные изменения продукции таких антител, как правило, не сказываются на ходе развития плода. Длительный подъем содержания эмбриотропных антител часто является признаком имеющихся или развивающихся аутоиммунных заболеваний и синдромов (в частности — антифосфолипидного синдрома). Стойкое (более 1,5-2 мес.) повышение сывороточного содержания всех или некоторых эмбриотропных антител может вести к бесплодию, патологии развития беременности и негативно влиять на формирование плода. Кратковременное снижение содержания всех эмбриотропных антител наблюдается после перенесенных острых инфекционных заболеваний. Спустя 2-3 нед. показатели содержания антител обычно возвращаются к нормальным значениям. Такие кратковременные изменения продукции таких антител, как правило, не сказываются на ходе развития плода. Длительное снижение продукции всех эмбриотропных антител является признаком общего снижения активности иммунной системы (иммунодепрессивных состояний). Причинной этого чаще всего служат хронические вирусные инфекции и хронические интоксикации. Длительное снижение продукции эмбриотропных антител нередко сопровождается невынашиванием беременности.
Как проводится исследование

Определение антител проводится в соответствии с алгоритмом
АФЛ включают в себя ряд аутоантител, но при исследовании оценивают не все иммуноглобулины. Необходимые показатели в анализе на АФЛ: антитела к кардиолипину IgM, а также IgG — волчаночный антикоагулянт.
Антитела к кардиолипину определяют при помощи твёрдофазного иммуноферментного анализа для b-2-гликопротеин 1- зависимых АФЛ. Стрип с 8 пробирками покрывают кардиолипином и добавляют b-2-гликопротеин. Если в образце крови присутствуют АФЛ, происходит связывание IgM с антигенами на твёрдой фазе. Для их обнаружения вводят фермент, окрашивающий пары антиген-антитело. По интенсивности окраски определяется концентрация антител к кардиолипину.
Также проводится исследование IgG, но помимо оценки связывания, учитываются следующие параметры:
- Определение фосфолипидзависимой фазы свёртывания крови с учётом тромбопластинового и каолинового времени, а также время свёртывания с использованием разведённого яда гадюки по тесту Рассела.
- Возможность коррекции удлинённого времени диагностических тестов при помощи добавления нормальной безтромбоцитарной плазмы.
- Оценка изменения времени диагностических тестов при смешивании образца крови с избыточной массой фосфолипидов.
Зачем сдавать два анализа на apl?
Кратковременное увеличение количества apl характерно для многих вирусных инфекционных болезней. В большинстве случаев параллельно с затуханием инфекции (7-21 день) у человека стабилизируется показатель антител. Данные скачки не приносят организму никакого вреда, даже если это беременная женщина.
Если же количество apl медленно увеличивается на 0,5 процента ежемесячно, то это может быть первым симптомом развивающихся или уже имеющихся аутоиммунных отклонений. Длительное повышение антифосфолипидов может инициировать бесплодие у женщин и мужчин, негативно повлиять на эмбрион и спровоцировать выкидыш.
Снижение показателей антител на короткое время возможно после перенесения человеком вирусного заболевания. На протяжении 21-28 дней данные показатели стабилизируются. Подобные изменения не несут негативного влияния на иммунитет и проходят незамеченными. Если же процесс отличается длительностью, это может сигнализировать о слабости иммунной системы. В большинстве случаев причиной отклонения считается вирусные недуги и интоксикации.
Из-за этих скачков нередко результат анализа на антифосфолипиды дает неправильную информацию. Чтобы избежать подобных казусов и зря не переживать, врачи советуют сдавать два анализа с промежутком в 1-1,5 месяца между процедурами.
Особенно важно проходить эти исследования беременным женщинам. Даже если до зачатия никаких отклонений не было, вынашивание ребенка может спровоцировать развитие АФС
Это объясняется серьезными гормональными изменениями в организме женщины.
Что такое антифосфолипидный синдром (АФС)
Под диагнозом АФС подразумевают комплекс нарушений, связанных с аутоиммунными реакциями на фосфолипидные структуры, содержащиеся в клеточных мембранах.
Точные причины развития синдрома неизвестны. Транзиторное возрастание уровней антител может отмечаться на фоне инфекционных заболеваний (гепатиты, ВИЧ, мононуклеоз, малярия).
Генетическая предрасположенность отмечается у носителей антигенов HLA DR4, DR7, DRw53, а также у родственников лиц, больных АФС.
Также высокие титры антител к фосфолипидам могут отмечаться на фоне ревматоидных артритов, болезни Шегрена, узелковых периартериитов, тромбоцитопеническх пурпур.
Отмечают и наличие связи АФС с СКВ (системная красная волчанка). Примерно у 5-10% пациентов с первичным антифосфолипидным синдромом в течение 10 лет развивается СКВ. В тоже время, у 3-50% больных СКВ в течение 10 лет развивается АФС.
Патогенез развития антифосфолипидного синдрома
По структуре и степени иммуногенности фосфолипиды разделяют на:
- «нейтральные» — эта группа включает фосфатидилхолин, фосфатидилэтаноламин;
- «отрицательно заряженные» — группа кардиолипина, фосфатидилсерина, фосфатидилинозитола.
К основным антителам, которые вступают в патологические реакции с «нейтральными» и «отрицательно заряженными» фосфолипидами, относят:
- волчаночные антикоагулянты;
- антитела к кардиолипину;
- бета2-гликопротеин-1-кофакторзависимые антифосфолипиды.
При взаимодействии антител с фосфолипидами, входящими с состав клеточных мембран эндотелиальных клеток сосудов, тромбоцитарных клеток, нейтрофилов и т.д., развиваются нарушения гемостаза, проявляющиеся повышенной свертываемостью крови и развитием множественных тромбов.
Симптомы антифосфолипидного синдрома
К основным признакам антифосфолипидного синдрома относят:
- множественные капиллярные, венозные и артериальные тромбозы (наиболее типичными проявлениями АФС являются рецидивирующие венозные тромбозы, поражающие глубокие вены голени, воротную печеночную вену, вены сетчатки);
- повторные эпизоды ТЭЛА (тромбоэмболия легочной артерии);
- синдром Бадда-Киари;
- недостаточность надпочечников;
- ишемические инсульты, транзиторные ишемические атаки;
- поражение ЦНС (рецидивирующие мигренозные приступы, прогрессирующая деменциея, нейросенсорная тугоухость и т.д.);
- поражение сердечно-сосудистой системы (инфаркт миокарда, ишемическая кардиомиопатия, артериальная гипертензия);
- острая почечная недостаточность;
- тромбоз мезентериальных сосудов;
- инфаркт селезенки;
- сетчатое ливедо (ретикулярная асфиксия относится к одному из наиболее показательных симптомов АФС).
У беременных женщин антифосфолипидный синдром приводит к самопроизвольному прерыванию беременности, развитию фетоплацентарной недостаточности, тяжелым гестозам (преэклампсии и эклампсии), внутриутробной гибели плода, преждевременным родам.
Что предполагает лечение данного синдрома
Для лечения, как правило, проводится антикоагулянтная терапия. Для профилактики и терапии применяют такие лекарственные препараты, как «Гепарин» наряду с «Варфарином» и «Аспирином». Неизвестно, возможно ли применение для лечения данного заболевания более новых антикоагулянтов, которыми ингибируется тромбин.
Прогноз при данной опасной патологии неоднозначен. Успех лечения зависит от многих факторов
Прежде всего, важно своевременно сдать кровь на исследование с целью определения уровня антител. Только на базе результатов и клинических проявлений может быть назначено правильное лечение врачом-ревматологом
Но при этом следует учитывать, что обязательно нужна будет консультация многих специалистов в связи с тем, что эта болезнь затрагивает многие органы.
Ни в коем случае не следует заниматься самолечением, поскольку это чревато тяжелыми последствиями для здоровья.
Если до беременности антитела к фосфолипидам не были повышены, может ли АФС развиться во время беременности?
Может. Основным (но не единственным) известным фактором риска в этом случае являются инфекции. Во время беременности иммунитет претерпевает изменения, и дремлющие инфекции могут обостриться. Образование антифосфолипидных антител является частью патогенеза инфекционного процесса при беременности. Антитела, вырабатывающиеся на фоне инфекции, приводят к развитию осложнений беременности и требует адекватной терапии. При антифосфолипидном синдроме, протекающем на фоне микоплазменной и смешанной инфекции, развиваются наиболее тяжелые, нередко необратимые, осложнения беременности.
Как проявляется у женщин
Половые органы у женщины содержат большое количество всевозможных иммунокомпетентных клеток. Натуральное попадание спермы в половые каналы может вызывать иммунный ответ. Правда, иммунологический процесс, происходящий в женском организме непосредственно после попадания спермы, еще недостаточно изучен. Формированию антител в женском организме, как правило, препятствуют разные механизмы, которые снижают иммунный ответ.
При овуляции меняется баланс Т-лимфоцитов. Например, уровень Т-хелперов понижается, а Т-супрессоров увеличивается. Помимо всего прочего, уменьшается общая концентрация иммуноглобулинов и С3 элемента системы комплемента. Важную роль в понижении иммунного ответа на сперматозоиды, как правило, играет мужской механизм защиты в форме сорбции и десоробции поверхностных антигенов при смене сред, а, кроме того, иммуносупрессивные факторы спермоплазмы.
Кроме этого, предполагается, что в маточную трубу попадает лишь небольшое количество генетически отобранных сперматозоидов, которые иммунологически отличаются от большинства, а остальные, в свою очередь, погибают и блокируют местный иммунитет.
Таким образом, антифосфолипидными антителами оказывается многогранное воздействие на систему гемостаза, повреждаются любые его защитные звенья в виде эндотелиального барьера, функции естественных антикоагулянтов, эндогенного фибринолиза. Помимо всего прочего активируется тромбоцитарное звено гемостаза с прокоагулянтными факторами.
Волчаночный тип — что это означает?
Это исследование антител, которые вырабатываются иммунной системой против своих фосфолипидов, играющих большую роль в образовании тромбов.
Как правильно подготовиться к сдаче крови на антифосфолипидные антитела волчаночного типа? Прежде всего, нельзя принимать пищу в течение трех часов перед процедурой, но зато можно выпить негазированную чистую воду. Также прекращают прием «Гепарина», а также его аналогов за пять дней до исследования. Исключают к тому же эмоциональное и физическое перенапряжение. Помимо всего прочего, нельзя курить за тридцать минут до анализа. Для чего применяется исследование на антифосфолипидные антитела волчаночного типа? Оно используется в следующих случаях:
Для выяснения причин тромбоза.
Для того чтобы установить причину прерывания беременности.
Чтобы выяснить, вызвано ли увеличение данных антител волчаночным антикоагулянтом либо другим особым ингибитором.
В целях диагностики антифосфолипидного синдрома (в сочетании с тестом на установление антикардиолипиновых антител).
В целях подтверждения присутствия волчаночного антикоагулянта.
В случае наличия тромбоза.
На фоне выявления продолжительного волчаночного антикоагулянта (в случаях положительных результатов анализы обычно повторяются через несколько недель в целях подтверждения присутствия волчаночного антикоагулянта).
Когда у пациентов обнаруживают антикардиолипиновые антитела.
Что такое антитела к фосфолипидам (АФЛ), анализ

Фосфолипиды клеточной мембраны
Антитела к фосфолипидам (АФЛ) — иммунный ответ организма, направленный против компонентов собственных клеток. Причина появления подобных антител чаще всего кроется в инфекционных заболеваниях и употреблении некоторых медицинских препаратов. Аутоиммунная атака угнетает функции клеток, провоцирует образование тромбов, нарушает течение беременности, негативно влияет на сосуды и нарушает естественный баланс во всём организме.
Фосфолипиды — органические вещества, входящие в состав мембран всех клеток человеческого тела. Они поддерживают гибкость клеточных мембран, защищают клетку от внешнего воздействия, способствуют транспортировке питательных веществ по организму, участвуют в процессе свёртываемости крови. Определить нарушения фосфолипидных компонентов из-за взаимодействия с АФЛ позволяют анализы на определение уровня IgM и IgG.
АФЛ способствуют развитию различных заболеваний, в зависимости от того, какой орган подвергается повреждению из-за их воздействия. АФЛ повреждают сосудистую стенку, изменяя её электрический заряд. При этом факторы свёртывания крови, не встречая сопротивления, «приклеиваются» к сосудам. Таким образом, запускается процесс тромбообразования в сосудах разной локации в организме. Разрушение фосфолипидов аутоантителами сопровождается комплексом симптомов, составляющих в целом антифосфолипидный синдром (АФС).
Синдром антифосфолипидных антител
Эта болезнь является аутоиммунной патологией, которая включает тромбоз, а при наличии беременности вызывает гибель плода. Данный синдром может вызываться разными антителами, воздействие которых направляется против нескольких фосфолипидных связывающих протеинов. Они, как правило, связываются с фосфолипидным компонентом мембраны, защищая его от чрезмерного активирования коагуляции.
Аутоиммунными антителами вытесняются защитные белки, и, таким образом, продуцируются прокоагулянтные поверхности эндотелиальных клеток, что в свою очередь вызывает венозные или артериальные тромбозы. Коагуляционные тесты могут быть пролонгированы из-за того, что фосфолипидные антитела попросту мешают скоплению коагуляционного фактора и процессу активации этих элементов, добавленных к плазме.
Волчаночный антикоагулянт является антифосфолипидным антителом, связывающимся с протеиновым комплексом. Первоначально данный синдром был признан у пациентов с красной волчанкой. Но такие больные в настоящее время составляют наименьшую долю пациентов с наличием аутоиммунных антител.